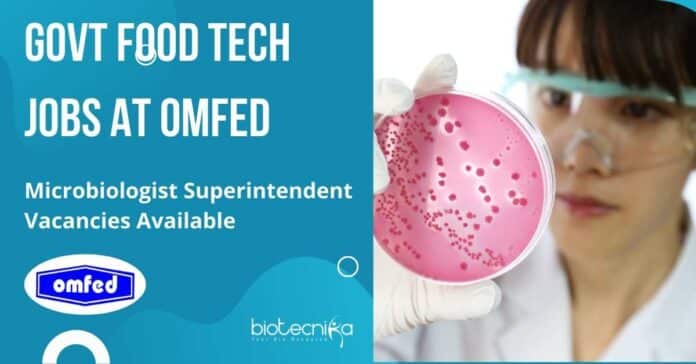

Govt Microbiology Job at OMFED, Applications Invited
Govt Microbiology Job at OMFED, Applications Invited. Dairy Microbiology/Dairy Technology/ Food Technology/Dairy Chemistry applicants are eligible to apply. Interested and eligible applicants can check out all of the details on the same below –
This job expires in
THE ODISHA STATE COOPERATIVE MILK PRODUCERS’ FEDERATION LTD.
The Odisha State Cooperative Milk Producers’ Federation (OMFED), set up by the Government of Odisha in 1980, with an aim to promote dairying as a source of livelihood in the rural parts of the State and propel Odisha towards self-reliance in milk and milk products.
The OMFED invites applications from eligible candidates for the position of Superintendent (Microbiologist).
Job Name – Superintendent (Microbiologist)
No. of Post – 03 (Three)
Age limit as of 30.09.2022 – 40 years.
Nature of employment – Contractual Engagement for a period of 3 years. The contract will be renewed every year subject to Satisfactory performance.
Monthly consolidated remuneration – The remuneration would be Negotiable, depending on experience and Suitability /Merit.
Qualification – Graduate/ Post Graduate in Dairy Microbiology/Dairy Technology/Food Technology/Dairy Chemistry/ from a recognized Institute/ University.
Experience – Minimum 3-5 years experience in UHT treated (aseptic) products testing experience Aseptic Pack seal integrity testing experience is compulsory. Preference will be given to having knowledge of ERP-SAP.
Job Description –
Key roles and Responsibilities –
- Undertake sampling and testing (bacteriological), of milk and milk products, packaging materials, treated and untreated water, and ingredients as per laid down procedures.
- Undertake random checking of physical tests of packed products
- Maintain and ensure housekeeping of laboratory and plants.
- Ensure maintenance of cleaning and operational parameters of plants and equipment.
- Conduct swab tests and rinse tests of plants and equipment.
- Maintain required records and registers.
- Coordinate with production for test reports.
- Implement the instructions and abide by the service rules and standing orders.
- Conduct bacteriological tests of all raw material, packing material, semi-finished products, finished products, water samples, equipment swabs, rinse tests and another related bacteriological testing in order to detect harmful microorganisms.
- Maintain inventory of all required culture and other microbiological testing-related materials.
- Isolate and make cultures of bacteria and other microorganisms in order to look at the growth of samples. Tracking environmental microorganism development.
- Prepare reports and recommendations based on research results. Observe microorganisms’ reactions to chemicals and other stimuli.
- Monitor and identify microorganisms.
- Provide scientific advice and consultation for continual improvement of UHT milk and product quality.
- Planning and carrying out trials.
- Root cause analysis, ensuring no failure. Need to work with a zero-tolerance target.
- Collecting samples from a variety of locations and recording, analysing and interpreting data.
- Ensure compliance to guidelines given by FSSAI and any other statutory requirements with regard to food safety in the food processing industry as per Rule.
- Ensure/maintain overall quality activities as per guidelines, quality assurance plans, SOP etc. for Plant through the quality control personnel engaged at the plant.
- To facilitate the requirements for ISO audit and ensure the audit must be carried out smoothly.
- Ensure that good manufacturing practices and good hygiene practices are followed to ensure hygiene and cleanliness.
- Any other duties assigned to him from time to time by the management.
Submission of application –
- Interested eligible candidates may apply in the prescribed Application Format, as per annexure and submit the same duly filled in and signed along with the proof of documents in a cover superscribed“APPLICATION FOR THE POST OF SUPERINTENDENT (MICROBIOLOGIST)” which should reach the Dy. General Manager (HR), OMFED, D-2, Sahidnagar, Bhubaneswar751007, Odisha on or before 07.10.2022. The application along with the requisite documents can also be submitted through e-mail at [email protected] or by post.
- The candidates already employed in Government/SemiGovernment/Central PSU/State PSU shall submit “No Objection Certificate” issued by their present employer at the time of personal interview.
- Internal candidates will apply through a proper channel.
- The applicant shall attach a self-attested copy of the Marksheet/Certificates/Documents regarding Age, Qualification, Working Experience, Present Remuneration& recent colour
passport size photograph with the Application Form. - Applications without supporting documents /incomplete/ not fulfilling the prescribed criteria in any respect shall be rejected.
Selection Process – Eligible candidates will be shortlisted and called for a personal interview. Selection will be made on the basis of career rating, review of past performance and personal interview by the Selection Committee.
General Conditions –
- Candidates are requested to the website of OMFED www.omfed.com for any notification, updates, results etc. relating to recruitment.
- At any stage of the recruitment process, if it is found that the candidate has furnished false or incorrect information, then the candidature/appointment of the candidate shall be cancelled.
- Application submitted after the due date shall be liable for rejection and cannot be entertained.
- Canvassing in any form will be viewed adversely and may lead to disqualification.
- Finally selected candidates shall have to produce the required documents at the time of joining as per the Rules of OMFED.
- The decision of Omfed Management will be final & binding on candidates in all matters relating to eligibility, acceptance or rejection of the application, selection of the candidate, cancellation of the recruitment process etc. No. enquiry/correspondence will be entertained in this regard.
- Any dispute arising out of this connection will be subject to the jurisdiction of appropriate Courts in Odisha.
- The engagement is purely contractual and temporary in nature. The candidates shall not have any right to regular employment in OMFED.
- Interested eligible candidates are requested to fill up the application form neatly without any overwriting or cutting which may lead to rejection of the application.
The last date for receiving an application is 07.10.2022
Click here for the notification and application format
Editor’s Note: Govt Microbiology Job at OMFED, Applications Invited. Please ensure that you are subscribed to the Biotecnika Times Newsletter and our YouTube channel to be notified of all of the latest in the industry. Follow us on our social media like Twitter, Telegram, Facebook and Instagram.

I found the job in ahemdabad and rajkot according to microbiology stream. If there any vacancy are available then please let me know.